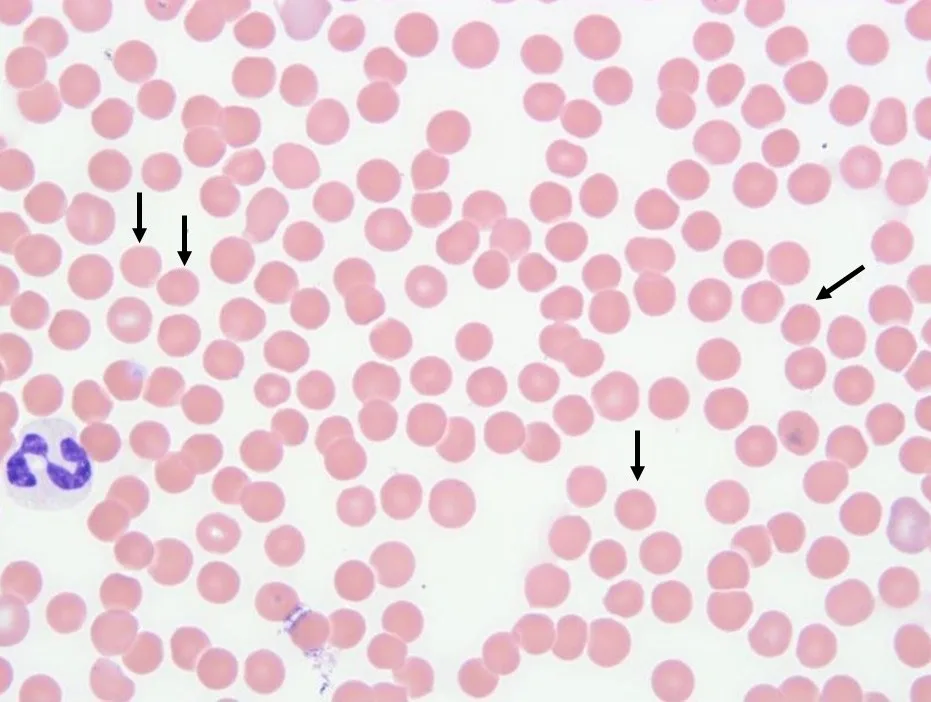
Blood smear of dog showing a single neutrophil and arrows pointing to several RBCs that lack normal central pallor.

Immune-mediated disorders are commonly diagnosed in dogs and can be classified as primary (unidentifiable underlying cause) or secondary (identifiable underlying cause).
Following are the most common primary immune-mediated disorders that affect dogs, according to the author.
1. Immune-Mediated Hemolytic Anemia
Immune-mediated hemolytic anemia (IMHA) is a common cause of anemia in dogs. Clinical signs can be caused by anemia (eg, lethargy, weakness, pale mucous membranes, collapse) or a compensatory response to tissue hypoxia (eg, tachypnea, tachycardia, bounding pulse). Pulmonary thromboembolism should be suspected in patients with sudden onset of severe dyspnea.
Initial diagnostics should include CBC (with blood smear evaluation) and a saline agglutination test using a 1:4 RBC dilution. The most common abnormal CBC finding is moderate to severe regenerative anemia; however, anemia may be nonregenerative if there is inadequate time to initiate an appropriate regenerative response or if there is immune-mediated destruction of erythrocyte precursor cells. Leukocytes (usually neutrophils) can be mildly to markedly increased, and platelet counts can vary. Mild thrombocytopenia can be present with IMHA, but concurrent immune-mediated thrombocytopenia (ITP; eg, Evans syndrome) is not considered unless there is marked thrombocytopenia.1
Abundant spherocytes on blood smear evaluation suggest primary or secondary IMHA, but their absence does not exclude this diagnosis (Figure 1). Blood smear evaluation can help identify underlying etiology, including parasites (eg, Mycoplasma haemocanis, Babesia spp, rickettsial diseases), Heinz bodies (suggestive of hemolysis secondary to oxidative damage), and schistocytosis (suggestive of a microangiopathic hemolytic process [eg, disseminated intravascular coagulation]).1
Blood smear evaluation of a dog with IMHA; spherocytes (globoid erythrocytes that lack an area of central pallor due to partial phagocytosis of antibody-coated membrane; arrows) can be seen.
Erythrocyte agglutination is common. A saline agglutination test and microscopic evaluation of a blood smear can help differentiate agglutination from rouleaux. A positive saline agglutination result is suggestive of IMHA, but a negative result does not rule out this diagnosis.1
Additional diagnostic tests should be performed to identify an underlying cause, including serum chemistry profile, urinalysis, diagnostic imaging (ie, thoracic radiography, lateral abdominal radiography, abdominal ultrasonography), and serologic and/or PCR testing for erythrocyte parasites (eg, M haemocanis, Babesia canis [especially in greyhounds], Babesia gibsoni [especially in pit bulls]). Immunologic testing using the direct antiglobulin test (ie, direct Coombs' test) may help support a tentative diagnosis of IMHA.1-3
Treatment includes immunosuppressive therapy, thromboprophylaxis, packed RBC transfusions (as needed based on severity of anemia and clinical signs4), and supportive care. Corticosteroids are the mainstay of immunosuppressive therapy, but additional immunosuppressive agents (eg, cyclosporine, mycophenolate mofetil, leflunomide, azathioprine) may be required to achieve appropriate levels of immunosuppression. Approximately 50% of dogs with IMHA are hypercoagulable at the time of diagnosis, and thromboprophylaxis therapy can reduce thromboembolic complications.
Prognosis is guarded, and a complete response to treatment can take weeks to months. The goal should be to reduce all immunosuppressive medications, but some patients require life-long therapy.
2. Immune-Mediated Thrombocytopenia
ITP is a common cause of thrombocytopenia in dogs. Many dogs with ITP have minimal or nonspecific clinical signs, but presence of hemorrhage is usually associated with surface bleeding (ie, petechiae, ecchymoses, melena, hematuria, epistaxis) rather than large-cavity hemorrhage (eg, hemoabdomen).5 There is risk for spontaneous bleeding when the platelet count is <30 × 103/µL to 50 × 103/µL, but hemorrhage is variable and unpredictable.6 Differential diagnoses should include consumption (ie, disseminated intravascular coagulation), decreased production (bone marrow disorders), infectious disease (eg, ehrlichiosis, Anaplasma platys, Rickettsia rickettsii), neoplasia, congenital macrothrombocytopenia, drug hypersensitivity (eg, trimethoprim/sulfamethoxazole), and artifact.
Thrombocytopenia is often the only abnormal finding on CBC, but anemia with concurrent hemorrhage may also be present. A manual platelet estimate should be performed on a stained blood smear, as platelets are prone to clumping. An estimated manual platelet count can be calculated by determining the average platelet number within at least 10 high-power (1,000× magnification) microscopic fields in the RBC monolayer, then multiplying the value by 15 and by 20 to obtain a final platelet count range (× 109/L). Once the platelet count is confirmed, additional diagnostic testing (eg, serum chemistry profile, urinalysis, vector-borne disease screening, thoracic and abdominal diagnostic imaging) should be performed to help identify the underlying cause. Identification of antiplatelet antibodies is not specific for ITP but can support diagnosis.5
Treatment is multimodal, involves immunosuppressive or immunomodulatory medications, and should only be initiated if the platelet count is <30 × 103/µL or there is clinical evidence of active bleeding. Glucocorticoids are the mainstay of immunosuppressive therapy, but additional immunosuppressive agents (eg, azathioprine, cyclosporine, mycophenolate mofetil, leflunomide) can be administered concurrently to achieve more effective immunosuppression or potentially allow a dose reduction in glucocorticoids to reduce drug-associated adverse effects.5 In many patients, a low dose of vincristine can increase circulating platelet numbers for 3 to 5 days following administration and shorten hospitalization time by ≈2 days.7 Cyclosporine and vincristine are both P-glycoprotein substrates and should therefore be used with caution if administered concurrently; caution is also advised if other P-glycoprotein substrates (eg, ketoconazole, ondansetron, loperamide) are concurrently administered.8
ITP is a serious but treatable disease, with a short-term (ie, 14 days to 8 months) survival rate of 74% to 97%.9
3. Immune-Mediated Polyarthritis
Immune-mediated polyarthritis (IMPA) is an inflammatory, noninfectious disease in dogs; has been associated with lameness, stiffness, fever, and joint pain (typically, carpi, tarsi, stifles, and elbows); and can be bilateral and symmetrical. Joint effusion and lameness do not occur in up to 25% of dogs with IMPA. Although most dogs with IMPA have nonerosive lesions, erosive lesions can occur with bone destruction. Differential diagnoses include septic arthritis, degenerative joint disease, neoplastic arthropathy, and trauma.10-12
Diagnosis should be based on cytologic evaluation of synovial fluid (obtained via joint taps) and radiographic evaluation of multiple joints. In dogs with IMPA, multiple joints are typically affected, synovial fluid protein concentration is >3 g/dL (reference interval, 1.5-3 g/dL), and total nucleated cell count is ≥3,000 cells/µL. Synovial fluid commonly contains >12% nondegenerative polymorphonuclear leukocytes.12 Carpal and tarsal joints are most commonly affected; however, aspiration of at least one larger joint (eg, stifle) is recommended if possible. Bacterial culture of the synovial fluid can help determine a possible infectious cause of IMPA.11
Immunosuppressive doses of corticosteroids are the mainstay of treatment. Adjunctive immunosuppressive therapy may be needed if corticosteroids alone do not achieve clinical remission. Leflunomide alone can also be effective if corticosteroids are ineffective or have intolerable adverse effects.11,13 Many dogs with IMPA appear painful, and controlling pain (eg, with gabapentin, amantadine, acetaminophen) can improve quality of life. NSAIDs are contraindicated if corticosteroids are administered.
Although prognosis for nonerosive IMPA is fair to good, dogs with erosive IMPA can be less responsive to therapy and have a poorer prognosis.12
4. Pemphigus Foliaceus
Pemphigus foliaceus is the most common autoimmune skin disease that affects dogs, particularly Akitas and chow chows.14 Clinical signs include facial lesions (ie, dorsal muzzle, planum nasale, periocular skin, ears) that can be bilateral and symmetrical (Figure 2). Regional (eg, footpads) or generalized lesions can also appear. Lesions are characterized by transient pustules that evolve into erosions and crusts. Alopecia and pruritus are occasionally seen.

A chow chow with bilateral and symmetrical lesions consistent with pemphigus foliaceus. Image provided by Juli Gunter, DVM, MS, DACVD
A presumptive diagnosis may be made based on clinical appearance, cytologic identification of acantholytic keratinocytes on impression smears of intact pustules, and histopathologic confirmation of subcorneal pustular dermatitis with acantholytic cells.14 Additional diagnostics should be performed to rule out other differential diagnoses.
Immunosuppressive doses of glucocorticoids are the most common initial treatment, but responses can vary. If glucocorticoids alone are ineffective, chlorambucil, cyclosporine, azathioprine, or mycophenolate mofetil can be given alone or in combination with glucocorticoids.14
Conclusion
Primary immune-mediated disorders are commonly diagnosed in dogs, and underlying etiology must be ruled out to establish a definitive diagnosis. Most of these disorders have variable responses to immunosuppressive therapy, and patients can become predisposed to opportunistic infections. Close monitoring is needed.
Listen to the Podcast
Dr. Thomason shares more of his expertise in this 2-part podcast series.